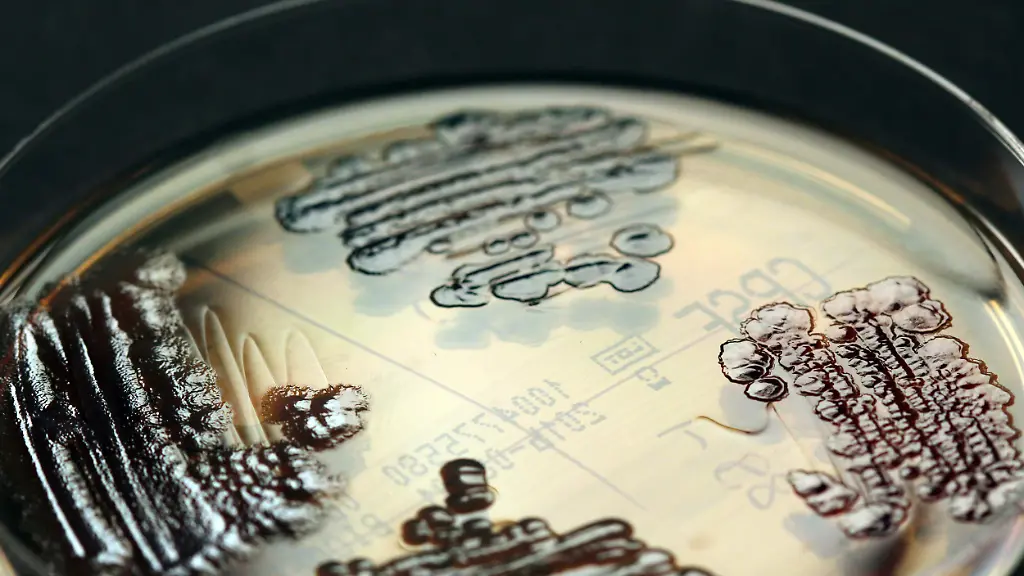
multiresistent

Immer mehr Resistenzen Warum es keine neuen Antibiotika gibt
Penicillin war einst die Wunderwaffe gegen Bakterien, heute ist es oft wirkungslos. Dass Keime zunehmend resistent werden, könnte langfristig mehr Todesfälle verursachen als Krebs. Neue Antibiotika müssen her - doch die Hürden sind groß.
Es ist ein Dilemma: Immer mehr Erreger sind gegen gängige Antibiotika resistent. Die Zahl der Krankenhauskeime wächst rasant; der Deutschen Gesellschaft für Krankenhaushygiene zufolge sterben allein in Deutschland jedes Jahr rund 40.000 Menschen daran. Trotzdem hat die Neuzulassung von Antibiotika drastisch abgenommen. "Die, die es gibt, stammen aus den 70er- und 80er-Jahren", sagt Dirk Heinz, Wissenschaftlicher Geschäftsführer am Helmholtz-Zentrum für Infektionsforschung (HZI) in Braunschweig. "In den letzten Jahrzehnten", so der Biochemiker, "haben wir keinen Vorsprung gegenüber den Mikroben gewonnen."
Um dem Problem der zunehmenden Resistenzen zu begegnen, gibt es mehrere, gleichzeitig einzuschlagende Wege. Einer etwa ist die zielgenaue Verschreibung von Antibiotika, basierend auf einer verbesserten, schnelleren Diagnostik. Ein anderer heißt ganz klar: Neue Antibiotika müssen her. Doch das ist nicht so einfach. Insbesondere drei Faktoren spielen bei der Entwicklung der neuen Medikamente eine Rolle: die Wirkstoffe, die Zeit und vor allem – wie so oft – das Geld.
Auf der Suche im thailändischen Regenwald
Antibiotika sind zumeist Naturstoffe. "80 Prozent der Antibiotika kommen aus natürlichen Quellen", sagt Marc Stadler, Leiter der Abteilung Mikrobielle Wirkstoffe am HZI. Stadler hat vor allem Pilze im Visier. Sie produzieren Antibiotika natürlicherweise, um sich gegen Bakterien durchzusetzen und deren Angriffe zu überleben. Dass sich umgekehrt auch die Bakterien zur Wehr setzen und solcherart mutieren, dass ihnen die Waffen der Pilze nichts mehr anhaben können, ist unvermeidlich. Die Resistenzbildung ist Teil der ökologischen Wechselbeziehungen.
Mit steigendem Einsatz der Antibiotika seit den 1940er-Jahren durch den Menschen mehren sich zwangsläufig auch die Resistenzen. Doch die Chancen für neue, hochwirksame antibiotische Stoffe stehen gut: Schätzungen zufolge gibt es bis zu fünf Millionen Pilzarten. Dass darunter vielversprechende Antibiotika-Lieferanten sind, ist wahrscheinlich. Allerdings muss man die erst einmal finden. Stadler ist dafür mit einer Forschungsgruppe im thailändischen Regenwald unterwegs. "Es ist eine Herausforderung, die Organismen zugänglich zu machen", sagt er.
15 Jahre von der Idee zum Medikament
Ist das gelungen und ein neuer Stoff entdeckt, kommt der Zeitfaktor ins Spiel. Insgesamt vergehen von der Idee bis zum Medikament an die 15 Jahre. Was in dieser Zeit noch alles geschieht? "Die meisten Naturstoffe, und das gilt auch für Antibiotika, müssen chemisch modifiziert werden", sagt Mark Brönstrup, Abteilungsleiter Chemische Biologie am HZI. Schließlich haben die Mikroorganismen die Stoffe nicht zum Wohle des Menschen entwickelt, sondern aus Eigennutz, als Überlebensvorteil. "Die Naturstoffe werden verändert, damit sie für den Einsatz im Menschen besser geeignet sind", erklärt Brönstrup. "Da geht es zum Beispiel um eine höhere Stabilität im Blutkreislauf, um höhere Wirkspiegel am Ort der Infektion und um eine bessere Verträglichkeit." Die chemische Optimierung ist kompliziert. "Das kostet einige Millionen Euro und dauert Jahre", merkt Brönstrup an.
Ist diese Hürde genommen, gilt es, die nächste zu bewältigen: Wie lässt sich der Wirkstoff in ausreichender Menge gewinnen? "Hier kann es zu Herstellungsproblemen kommen", sagt der Wissenschaftliche Geschäftsführer des HZI, Dirk Heinz, "denn von einem Antibiotikum müssen Tonnen produziert werden." Und noch etwas ist zu bedenken: Der Wirkstoff muss in Tablettenform gebracht werden können. "In vielen Fällen ist das unmöglich", so Heinz. "Dann müsste man das Mittel intravenös verabreichen, aber das ist für den Patienten zu Hause nicht praktikabel." Von der Pharmaindustrie, die das Antibiotikum letztlich produziert und auf den Markt bringt, werden daher, wie Heinz betont, "weit über 50 Prozent der wissenschaftlichen Entdeckungen abgelehnt". Sehr häufig also führt die Forschung nicht zum Ziel.
Zu wenig Verkaufsvolumen
Was neue Antibiotika anbelangt, zeigt die Pharmaindustrie ohnehin kaum Interesse. Die Entwicklung ist teuer: Von 200 bis 300 Millionen Euro ist die Rede – pro Medikament. Diese Summe ist die größte Hürde, wenn es um neue antibiotische Wirkstoffe für den Menschen geht. Die Industrie ist nicht bereit, dafür derart tief in die Tasche zu greifen. Dahinter steckt keine Boshaftigkeit, sondern schlicht wirtschaftliches Denken. Neue Antibiotika rechnen sich womöglich nicht. "Es ist nicht klar, ob man damit Geld verdient", sagt Wissenschaftler Brönstrup.
Das mag überraschen. Der Anwendungsbereich der Antibiotika ist groß; viele Menschen sind immer wieder einmal darauf angewiesen. Brönstrup jedoch weist auf die kurze Behandlungsdauer hin. Ein Antibiotikum nimmt der Patient meist nur eine Woche. Auf Diabetes-Mittel hingegen – das zum Vergleich – ist er bei entsprechenden Symptomen lebenslang angewiesen. Hinzu kommt: Eben wegen der unvermeidlichen Resistenzen würde ein neues Antibiotikum nicht großzügig, sondern mit Bedacht eingesetzt werden. "Man würde es wohl eher selten verschreiben", sagt Brönstrup, "und es als Reserve-Antibiotikum zurückhalten. Wenn es besonders gut ist, soll es eben möglichst lange wirksam sein." Das Fazit der Pharmafirmen ist da schnell gezogen: zu wenig Verkaufsvolumen.
"Ein formidables Problem"
Für die Wissenschaft bedeutet das: Ohne öffentliche Gelder geht es nicht. Seit den 70er-Jahren wurde die Forschung an Antibiotika nicht mehr gefördert. Erst jetzt, da die G7-Staats- und Regierungschef gemeinsame Maßnahmen zur Bekämpfung von Resistenzen beschlossen haben, nehmen die Institute die Arbeit an neuen Wirkstoffen allmählich wieder auf.
Angesichts der Entwicklungsdauer drängt die Zeit - auch wenn HZI-Geschäftsführer Heinz aktuell nicht von einer Antibiotika-Krise sprechen will. "Es gibt noch viele wirksame Antibiotika", sagt er. "Aber man muss zunehmend auf die ganz harten zurückgreifen – die mehr Nebenwirkungen haben." Mit Blick auf die Zukunft, etwa auf das Jahr 2050, sagt der Biochemiker: "Wenn wir weiterhin keine neuen Antibiotika haben, wird sich das deutlich auf die Sterberate auswirken." Irgendwann muss sich also auch die Industrie wieder auf diesem Gebiet engagieren – vorausgesetzt, es werden neue Wirkstoffe entdeckt, die die Anforderungen der Pharmafirmen erfüllen. "Die Antibiotika-Entwicklung", bilanziert Heinz, "ist ein formidables Problem. Es ist nicht hoffnungslos - aber eine Herausforderung."